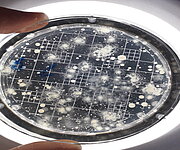

- Home
- Information
- Annual report 2025
-
Solutions
-
 Water analysis Conducting and evaluating physical-chemical and microbiological water testing in accordance with German Drinking Water Ordinance and other regulations.
Water analysis Conducting and evaluating physical-chemical and microbiological water testing in accordance with German Drinking Water Ordinance and other regulations. -
![[Translate to English:] Prüfstelle-Produktprüfung_Teststand Test centre and product testing](/fileadmin/_processed_/0/9/csm_TZW-Karlsruhe_Pruefung_Geraete-Teststand_377188946c.jpg) Testing of products and devices Initial testing of products and materials in contact with drinking water. The test centre is accredited for more than 200 product standards.
Testing of products and devices Initial testing of products and materials in contact with drinking water. The test centre is accredited for more than 200 product standards. -
 Treatment technologies Develop sustainable water supply concepts. Implement, monitor and optimise new technologies. Test and further develop existing treatment methods.
Treatment technologies Develop sustainable water supply concepts. Implement, monitor and optimise new technologies. Test and further develop existing treatment methods. -
 Micropollutants and microorganisms Development and improvement of determination procedures. Investigating occurrence, behaviour and fate of inorganic and organic trace substances.
Micropollutants and microorganisms Development and improvement of determination procedures. Investigating occurrence, behaviour and fate of inorganic and organic trace substances. -
 Network management and drinking water installation Advice on safeguarding the quality of drinking water in the distribution system, support in the development of specific network management strategies.
Network management and drinking water installation Advice on safeguarding the quality of drinking water in the distribution system, support in the development of specific network management strategies. -
 Risk management Supporting water supply companies in setting up continuous risk management for water supply facilities, based on our comprehensive expertise.
Risk management Supporting water supply companies in setting up continuous risk management for water supply facilities, based on our comprehensive expertise. -
 Drinking water catchments and resources Protection of drinking water resources by assessing potential hazards in water catchment areas, catalogues of measures, monitoring concepts, databases.
Drinking water catchments and resources Protection of drinking water resources by assessing potential hazards in water catchment areas, catalogues of measures, monitoring concepts, databases. -
 Environmental biotechnology and contaminated sites Environmental biotechnology to improve water quality. Degradation processes for water purification. Concepts and studies for pollutant contamination.
Environmental biotechnology and contaminated sites Environmental biotechnology to improve water quality. Degradation processes for water purification. Concepts and studies for pollutant contamination. -
 Digitalisation Solving complex questions and problems of water supply companies in digitalisation through technical support or practical research projects.
Digitalisation Solving complex questions and problems of water supply companies in digitalisation through technical support or practical research projects. -
 Practical projects Research and practice, water supply, scientific and technical expertise, technology concepts, resource protection, distribution network, digitalisation.
Practical projects Research and practice, water supply, scientific and technical expertise, technology concepts, resource protection, distribution network, digitalisation.
-
-
Research
-
 Resource protection Sustainable resource protection as an important factor for safe drinking water supply, management of hazards and risks in water catchment areas.
Resource protection Sustainable resource protection as an important factor for safe drinking water supply, management of hazards and risks in water catchment areas. -
 Environmental biotechnology Technical and biological methods for the elimination of microorganisms, microbiological degradation processes, risk assessment of microbial contamination.
Environmental biotechnology Technical and biological methods for the elimination of microorganisms, microbiological degradation processes, risk assessment of microbial contamination. -
 Microorganisms Application and development of reliable detection methods for microorganisms in drinking water, evaluation of disinfection and treatment measures.
Microorganisms Application and development of reliable detection methods for microorganisms in drinking water, evaluation of disinfection and treatment measures. -
 Micropollutants Reliable and sensitive determination of trace substances and microplastics, investigation of the behaviour in the water cycle, qualified risk assessment.
Micropollutants Reliable and sensitive determination of trace substances and microplastics, investigation of the behaviour in the water cycle, qualified risk assessment. -
 Waste water and water cycle Development of integrated water supply and waste water disposal concepts, Utilisation of biodegradation processes to eliminate persistent substances.
Waste water and water cycle Development of integrated water supply and waste water disposal concepts, Utilisation of biodegradation processes to eliminate persistent substances. -
 New technologies and products Technologies and products for the treatment, disinfection and post-treatment of drinking water, testing for performance, safety and robustness.
New technologies and products Technologies and products for the treatment, disinfection and post-treatment of drinking water, testing for performance, safety and robustness. -
 Asset management and infrastructure Development of asset management strategies to ensure a stable supply of high-quality drinking water, assessment of the condition of pipeline networks.
Asset management and infrastructure Development of asset management strategies to ensure a stable supply of high-quality drinking water, assessment of the condition of pipeline networks. -
 Digitalisation and Management Digitalisation in the areas of data collection, data management, data-driven applications and AI for the water supply.
Digitalisation and Management Digitalisation in the areas of data collection, data management, data-driven applications and AI for the water supply.
-
- Projects
- About TZW
- Information
- Careers

![[Translate to English:] Plate heat exchanger](/fileadmin/_processed_/6/2/csm_shutterstock_2125937294_Plattenwaermetauscher_d2cc672a8a.jpg)








![[Translate to English:] [Translate to English:]](/fileadmin/_processed_/1/0/csm_Projekt_WaMi_01_06de125bdd.png)

![[Translate to English:] Stimulation of aerobic TCE, cDCE and VC degradation with oxygen](/fileadmin/_processed_/d/b/csm_Bild2_77b4e837c6.png)